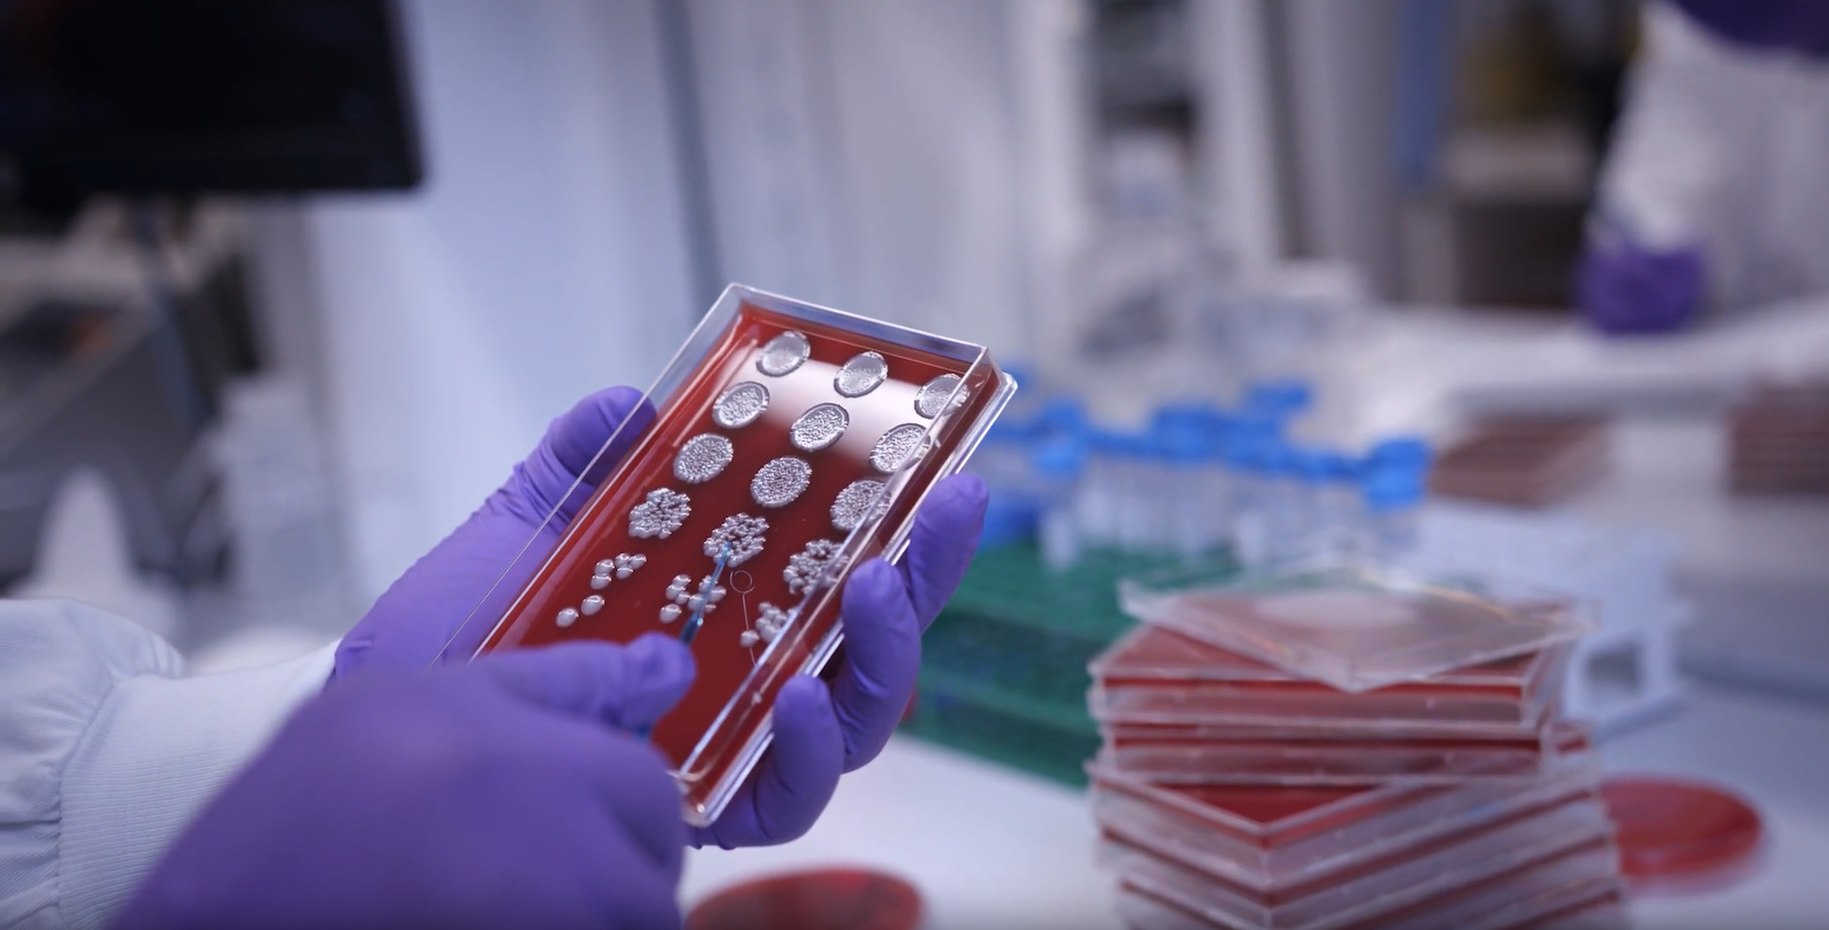

We unite science, technology and talent to get ahead of disease together.
We are GSKScroll to explore
We aim to positively impact the health of 2.5 billion people by the end of the decade.
Getting ahead of disease in markets worldwide Outstanding people GSK people Innovation strategic global R&D hubs in US, UK and Belgium vaccines and medicines in development in the Access to Medicine Index for 8th consecutive time Performance group turnover in 2023, AER 3% CER 5%Find out more about our board and global leadership team who have overall responsibility for delivering our ambition, strategy and culture.

We have policies in place across GSK to ensure we meet the high standards we set ourselves as a company, and those that are expected of us externally.






Behind the science

Meet the world-leading scientists who are uniting science, technology and talent to get ahead of disease together.
Our people are central to our success. That’s why we’re inspired to help the most diverse and outstanding talent to thrive and be happy at work, in a culture where we’re ambitious for patients, accountable for impact and do the right thing.
Great place to work
Veterans at GSK
Innovating together 2022

At GSK we unite science, technology and talent to get ahead of disease together

To get ahead of disease in the right way means being conscious of the impact we have on the world around us

It began when Plough Court Pharmacy was established in 1715. Discover GSK’s journey to the company we are today
This is our global website, intended for visitors seeking information on GSK's worldwide business. Our market sites can be reached by visiting our location selector.
© 2001-2024 GSK plc. All rights reserved. Trade marks are owned by or licensed to the GSK group of companies.
GSK plc. Registered in England and Wales No. 3888792.
Registered office: 980 Great West Road, Brentford, Middlesex, TW8 9GS, United Kingdom.